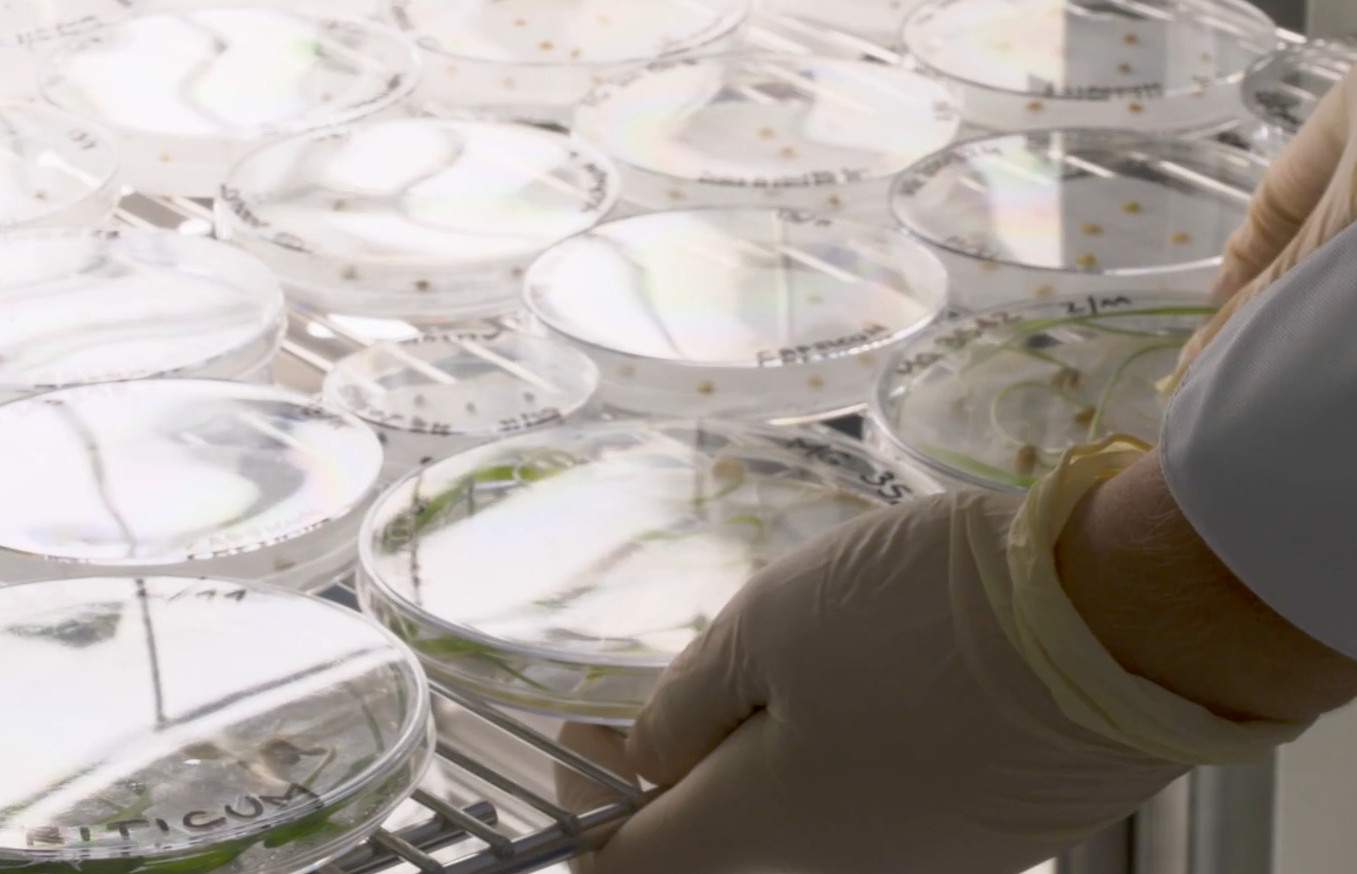
Doomsday Vault: Location of unique facility and how to visit

Doomsday Vault: Location of unique facility and how to visit
 The Doomsday Vault is fascinating in its simplicity (photo: Getty Images)
The Doomsday Vault is fascinating in its simplicity (photo: Getty Images)
On an archipelago in the Arctic Ocean, away from the eyes of most travelers, there is a unique Svalbard Global Seed Vault, or as it is also called, the Doomsday Vault.
RBC-Ukraine dwells on this vault, what makes it unique, and whether tourists are allowed to visit it.
Contents
Svalbard Global Seed Vault
The Svalbard Global Seed Vault is a unique structure designed to preserve the gene pool of modern grain crops.
Like a black box, it serves humanitarian purposes and is part of the international system for the conservation of plant genetic diversity managed by the United Nations Food and Agriculture Organization (FAO).
 The exterior of the Svalbard Global Seed Vault (screenshot: seedvault.no/about/the-seeds)
The exterior of the Svalbard Global Seed Vault (screenshot: seedvault.no/about/the-seeds)
It offers safe, free, and long-term storage of duplicate seeds from all genebanks and countries that participate in the global community's joint efforts to secure the world's future food supply.
The Svalbard Global Seed Vault could play a role in the event of a global catastrophe, which is why some people also call it the Doomsday Vault.
 Entrance to the Doomsday Vault (screenshot: seedvault.no/about/the-seeds)
Entrance to the Doomsday Vault (screenshot: seedvault.no/about/the-seeds)
At the same time, it is believed that its value is much more in providing backup copies of individual seed collections - in case the original samples (and their duplicates in conventional genebanks) are lost due to:
- natural disasters
- human conflicts
- change of policy
- mismanagement or any other circumstances
 Shipment of seed samples (screenshot: seedvault.no/about/the-facility)
Shipment of seed samples (screenshot: seedvault.no/about/the-facility)
What is hidden in the Doomsday Vault
The Svalbard Global Seed Vault stores seeds considered valuable for food and agriculture, as well as important for research, plant breeding, and education (following international law).
The specimens of more than 5000 plant species stored there are samples of seeds with unique genotypes. They include:
- crop varieties
- crop varieties from farmers' land
- breeding material
- wild plants (related to new crop varieties and can be gene donors for them)
Sprouted seeds (screenshot: seedvault.no/about/the-seeds)
Sprouted seeds (screenshot: seedvault.no/about/the-seeds)
According to the Svalbard Global Seed Vault, the largest collection of samples in the vault are rice, wheat, and barley varieties:
- more than 150,000 wheat and rice samples
- about 80,000 barley samples
 Some of the crops represented in the repository (screenshot: seedvault.no/about/the-seeds)
Some of the crops represented in the repository (screenshot: seedvault.no/about/the-seeds)
Other crops widely represented in the Doomsday Vault:
- sorghum (more than 50,000 accessions)
- phaseolus bean species (more than 40,000 accessions)
- corn (more than 35,000 specimens)
- cowpea from the legume family (more than 30,000 copies)
- soybeans (more than 25,000 copies)
- Kikuyu grass (more than 20,000 specimens)
- chickpeas or chickpeas (more than 20,000 specimens)
- potatoes, peanuts, cajanus beans or pigeon peas, oats, rye, alfalfa, Tritikosecale, and Brassica cereal hydrides (10,000 to 20,000 seed samples)
Vault location and tourism
It is believed that the idea of creating a Svalbard Global Seed Vault belongs to conservationist Cary Fowler. The initiative began to be discussed in the 1980s.
In 1984, the Nordic Gene Bank (now NordGen) created a backup seed repository in an abandoned coal mine near the Norwegian city of Longyearbyen (in a steel container inside coal mine No. 3), but the idea of creating a more global repository continued to evolve.
 Longyearbyen (photo: commons.wikimedia.org)
Longyearbyen (photo: commons.wikimedia.org)
Scientists noted that permafrost (with a temperature of about -3.5°C) is not optimal for storing global genetic heritage. In addition, the storage of the Scandinavian seed collection in a coal mine, where high levels of hydrocarbon gases were periodically recorded, was not safe enough.
Given this, a decision was made to create a new design in virgin rock - with additional cooling (to reduce the temperature to the required level, the standard for genebanks) and without coal.
In October 2004, the Norwegian government pledged to finance and create a Global Seed Vault in the mountains of Svalbard (also called Svalbard). This is a Norwegian archipelago located in the Arctic Ocean at a distance of 1300 km from the North Pole.
 Location of the archipelago (map: google.com/maps)
Location of the archipelago (map: google.com/maps)
In June 2006, the Prime Ministers of Norway, Sweden, Finland, Denmark, and Iceland laid the foundation stone for the future vault, and on February 26, 2008, the Svalbard Global Seed Vault was officially opened, carved into untouched solid rock.
The seed storage area is located more than 100 meters deep in the mountain and under layers of rock 40 to 60 meters thick. It has an additional cooling system to reduce the stable temperature of minus 3-4°C to the required minus 18°C.
The seed warehouse consists of three halls (measuring about 9.5 by 27 meters), each of which can hold about 1.5 million seed samples. That is, the total capacity of the storage is 4.5 million specimens.
Currently, the Svalbard Global Seed Vault has more than 1,200,000 seed samples (out of three halls, only one is used, cooled to minus 18°C, and equipped with racks for seedboxes). As of the beginning of 2018, 4,231 samples of Ukrainian crops (including varieties of Myronivka breeding wheat developed by our scientists) were also stored there.
For better storage, the seeds are packed in sealed bags of three layers of foil and then placed in plastic containers on metal racks. Low temperature and limited oxygen access ensure low metabolic activity and slow down seed aging.
 Metal racks in the storage facility (screenshot: seedvault.no/about/the-facility)
Metal racks in the storage facility (screenshot: seedvault.no/about/the-facility)
The entrance portal is a simple concrete structure that has become a world icon over time (partly due to the illuminated fiber-optic art installation Eternal Repercussion by Norwegian artist Dyveke Sanne).
 The outer portal is the entrance to the vault (photo: seedvault.no/about/the-facility)
The outer portal is the entrance to the vault (photo: seedvault.no/about/the-facility)
Visitors to Svalbard often approach the Doomsday Vault to take selfies or group photos and check off that they have been there. At the same time, travelers and tourists are not allowed inside the shelter.
Instead, anyone can take a walk through the repository online thanks to a special virtual tour.
 The beginning of the virtual tour (screenshot: seedvaultvirtualtour.com)
The beginning of the virtual tour (screenshot: seedvaultvirtualtour.com)
Sources: Svalbard Global Seed Vault, Wikipedia, seedvaultvirtualtour.com, Google Maps, Motherboard YouTube channel.


